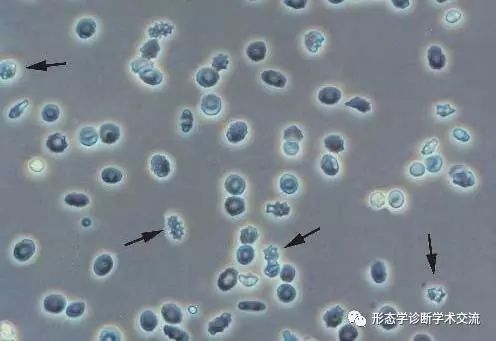
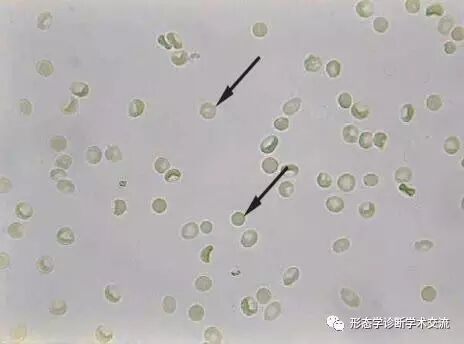

2007年卫生部尿液沉渣形态学检查室间质量评价及答案
1.箭头所指名称:胆固醇结晶

2.箭头所指名称:脂肪滴

3.箭头所指名称:颗粒管型

4.箭头所指名称:红细胞

5.箭头所指名称:扁平上皮细胞(表层)

6.箭头所指名称:透明管型

7.箭头所指名称:移行上皮细胞(表层)移行上皮细胞(中层)移行上皮细胞(深层)

8.箭头所指名称:蜡样管型

9.箭头所指名称:白细胞

10.箭头所指名称:真菌

2008年卫生部尿液沉渣形态学检查室间质量评价及答案
1.箭头所指目标:尿酸铵结晶

2.箭头所指目标:红细胞

3.箭头所指目标:胱氨酸结晶

4.箭头所指目标:移行上皮细胞

5.箭头所指目标:移行上皮癌细胞、扁平上皮癌细胞、腺癌细胞

6.箭头所指目标:透明管型

7.箭头所指目标:红细胞管型

8.箭头所指目标:颗粒管型

9.箭头所指目标:细菌
10.箭头所指目标:红细胞
2009年卫生部尿液沉渣形态学检查室间质量评价及答案
1、箭头所指细胞内结构的名称:真菌

2、箭头所指细胞内结构的名称:

3、箭头所指细胞内结构的名称:颗粒管型 蜡样管型

4、箭头所指细胞内结构的名称:白细胞

5、箭头所指细胞内结构的名称:透明管型

6、箭头所指细胞内结构的名称:肾小管上皮细胞

7、箭头所指细胞内结构的名称:磷酸氨镁结晶(三联磷酸盐)

8、箭头所指细胞内结构的名称:红细胞
9、箭头所指细胞内结构的名称:扁平上皮细胞(表层)扁平上皮细胞(中层)

10、箭头所指细胞内结构的名称:脂肪管型
2010年卫生部尿液沉渣形态学检查室间质量评价及答案

2、箭头所指细胞内结构的名称:白细胞

3、箭头所指细胞内结构的名称:胆红质结晶

4、箭头所指细胞内结构的名称:红细胞

5、箭头所指细胞内结构的名称:红细胞管型

6、箭头所指细胞内结构的名称:颗粒管型

7、箭头所指细胞内结构的名称:尿酸结晶

8、箭头所指细胞内结构的名称:移行上皮细胞(深层)

9、箭头所指细胞内结构的名称:移行上皮细胞(中层)

10、箭头所指细胞内结构的名称:细菌

11、箭头所指细胞内结构的名称:原虫

12、箭头所指细胞内结构的名称:精子

13、箭头所指细胞内结构的名称:肾小管上皮细胞

14、箭头所指细胞内结构的名称:白细胞管型

15、箭头所指细胞内结构的名称:纤维丝(如棉花丝等)

2011年卫生部尿液沉渣形态学检查室间质量评价及答案

2、箭头所指细胞内结构的名称:蜡样管型

3、箭头所指细胞内结构的名称:红细胞

4、箭头所指细胞内结构的名称:真菌

5、箭头所指细胞内结构的名称:白细胞管型

6、箭头所指细胞内结构的名称:图片细胞形态不够典型,结果分歧较大,故取消对该图片的评价

7、箭头所指细胞内结构的名称:尿酸结晶

8、箭头所指细胞内结构的名称:移行上皮细胞(中层) 移行上皮细胞(深层)

9、箭头所指细胞内结构的名称:白细胞

10、箭头所指细胞内结构的名称:脂肪颗粒细胞

11、箭头所指细胞内结构的名称:移行上皮癌细胞 扁平上皮癌细胞 腺癌细胞

12、箭头所指细胞内结构的名称:肾小管上皮细胞

13、箭头所指细胞内结构的名称:扁平上皮细胞(表层)

14、箭头所指细胞内结构的名称:颗粒管型

15、箭头所指细胞内结构的名称:胱氨酸结晶

2012年卫生部尿液沉渣形态学检查室间质量评价及答案
1、箭头所指细胞内结构的名称:红细胞管型 血液管型

2、箭头所指细胞内结构的名称:草酸钙结晶

3、箭头所指细胞内结构的名称:尿酸结晶

4、箭头所指细胞内结构的名称:移行上皮细胞(表层)

5、箭头所指细胞内结构的名称:颗粒管型

6、箭头所指细胞内结构的名称:扁平上皮细胞(表层)

7、箭头所指细胞内结构的名称:尿酸铵结晶

8、箭头所指细胞内结构的名称:肾小管上皮细胞

9、箭头所指细胞内结构的名称:透明管型

10、箭头所指细胞内结构的名称:纤维丝

11、箭头所指细胞内结构的名称:移行上皮细胞(中层)

12、箭头所指细胞内结构的名称:蜡样管型

13、箭头所指细胞内结构的名称:酪氨酸结晶

14、箭头所指细胞内结构的名称:上皮细胞管型 白细胞管型 混合细胞管型


2013年卫生部尿液沉渣形态学检查室间质量评价及答案
1、箭头所指细胞内结构的名称:移行上皮细胞(中层)

2、箭头所指细胞内结构的名称:颗粒管型

3、箭头所指细胞内结构的名称:白细胞管型 混合细胞管型

4、箭头所指细胞内结构的名称:红细胞

5、箭头所指细胞内结构的名称:肾小管上皮细胞

6、箭头所指细胞内结构的名称:扁平上皮细胞(表层)

7、箭头所指细胞内结构的名称:白细胞

8、箭头所指细胞内结构的名称:尿酸结晶

9、箭头所指细胞内结构的名称:草酸钙结晶

10、箭头所指细胞内结构的名称:移行上皮细胞(表层)

11、箭头所指细胞内结构的名称:胆固醇结晶

12、箭头所指细胞内结构的名称:脂肪颗粒细胞 复粒细胞

13、箭头所指细胞内结构的名称:蜡样管型

14、箭头所指细胞内结构的名称:磷酸氨镁结晶(三联磷酸盐)


2014年卫生部尿液沉渣形态学检查室间质量评价及答案
序号 | 图片 | 说明 |
2014501 |
| 透明管型 |
2014502 |
| 红细胞 |
2014503 |
| 尿酸铵结晶 |
2014504 |
| 白细胞管型 |
2014505 |
| 移行上皮细胞(表层)移行上皮细胞(底层) |
2014506 |
| 鳞状上皮细胞 |
2014507 |
| 磺胺类结晶 |
2014508 |
| 白细胞 |
2014509 |
| 磷酸钙结晶 |
2014510 |
| 颗粒管型 |
2014511 |
| 草酸钙结晶 |
2014512 |
| 胆红质结晶 |
2014513 |
| 血液管型 |
2014514 |
| 精子 |
2014515 |
|
2015年卫生部尿液沉渣形态学检查室间质量评价及答案
序号 | 图片 | 说明 |
2015501 |
| 红细胞 |
2015502 |
| 颗粒管型 |
2015503 |
| 脂肪颗粒细胞 复粒细胞 |
2015504 |
| 透明管型 |
2015505 |
| 尿酸结晶 |
2015506 |
| 鳞状上皮细胞 扁平上皮细胞(表层)扁平上皮细胞 (中层)扁平上皮细胞(深层) |
2015507 |
| 磷酸氨镁结晶(三联磷酸盐) |
2015508 |
| 吞噬细胞 |
2015509 |
| 血液管型 |
2015510 |
| 粘液丝 |
2015511 |
| 上皮细胞管型 |
2015512 |
| 白细胞 |
2015513 |
| 脂肪滴 |
2015514 |
| 移行上皮细胞(表层) |
2015515 |
|
2016年卫生部尿液沉渣形态学检查室间质量评价及答案
序号 | 图片 | 说明 |
2016501 |
| 白细胞 |
2016502 |
| 尿酸结晶 |
2016503 |
| 红细胞 |
2016504 |
| 白细胞管型 |
2016505 |
| 磷酸钙结晶 |
2016506 |
| 颗粒管型 |
2016507 |
| 鳞状上皮细胞 |
2016508 |
| 真菌 |
2016509 |
| 草酸钙结晶 |
2016510 |
| 蜡样管型 |
2016511 |
| 磷酸氨镁结晶(三联磷酸盐) |
2016512 |
| 移行上皮细胞(中层) |
2016513 |
| 透明管型 |
2016514 |
| 移行上皮细胞(表层) |
2016515 |
| 血液管型 |
2017年卫生部尿液沉渣形态学检查室间质量评价及答案





参考答案:
2017502 胆固醇结晶
2017503 颗粒管型
2017504 红细胞
2017505 磷酸钙结晶
2017506 血液管型
2017507 鳞状上皮细胞
2017508 真菌
2017509 移行上皮细胞(底层)
2017510 磷酸铵镁结晶(三联磷酸盐)
2017511移行上皮细胞(中层)
2017512 蜡样管型
2017513 移行上皮细胞(表层)
2017514 胆红素结晶
2017515 透明管型
2018年卫生部尿液沉渣形态学检查室间质量评价及答案
序号 | 图片 | 说明 |
2018501 |
| 红细胞 |
2018502 |
| 白细胞管型 |
2018503 |
| 鳞状上皮细胞 |
2018504 |
| 胆固醇结晶 |
2018505 |
| 颗粒管型 |
2018506 |
| 胆红素结晶 |
2018507 |
| 真菌 |
2018508 |
| 白细胞 |
2018509 |
| 透明管型 |
2018510 |
| 红细胞管型、血液管型 |
2018511 |
| 尿酸铵结晶 |
2018512 |
| 蜡样管型 |
2018513 |
| 磷酸铵镁结晶(三联磷酸盐) |
2018514 |
| 脂肪滴 |
2018515 |
|
来源:微信公众号“血液病综合诊断学术交流”